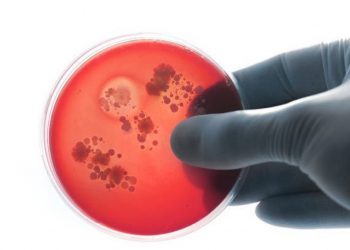

Shëndet
Lajme.al ju sjell edhe këshilla të rëndësishme në mënyrë që jeta juaj të bëhet sa më e shëndetshme. Lexoni këshilla shëndetësore nga doktorë të njohur nga vendi dhe bota.
Përgatiti mëngjes për fëmijët e saj dhe i vrau ata, me një gabim që të gjithë ne e bëjmë
Josefina, një nënë e dy fëmijëve, u zgjua herët një ditë dhe shkoi në treg për të marrë ushqime për...
Lexo më shumëDetailsKujdes çka hani dhe pini, kjo video do t’ju bëjë të mendoni dy herë në lidhje me ushqimet (VIDEO)
Çdo ditë jemi të ekspozuar ndaj artikujve të cilët na alarmojnë dhe na këshillojmë se çfarë duhet dhe çfarë nuk...
Lexo më shumëDetailsMjekët holandezë, alarm për sëmundjen e re vdekjeprurëse në Europë
Mjekët holandezë paralajmëruan për fuqizimin e baktereve të meningokut, të cilat mund të shkaktojnë helmim të rëndë të gjakut dhe...
Lexo më shumëDetailsTri gjërat që duhet t’i largoni menjëherë nga shtëpia, të rrezikshme për shëndetin tuaj (FOTO)
Ne përdorim shumë gjëra në shtëpi çdo ditë, për qëllime të ndryshme. Shumica e njerëzve i përdorin ato ashtu si...
Lexo më shumëDetails6 arsyet e çuditshme që ju bëjnë të shtoni në peshë edhe pse nuk e teproni me ushqimin
Ngrënia pa kriter nuk është ndër arsyet e vetme përse një person shton peshë. Kur të mësoni sesa shkaqe të...
Lexo më shumëDetailsU ulën temperaturat, tani duhet të hani fasule, do mahniteni nga ajo çfarë do mësoni mbi këtë ushqim
Në dimër fasulet janë ndoshta ushqimi me i përdorshëm i shqiptarëve. Por duke ditur vetitë shëndetësore që ne marrim prej...
Lexo më shumëDetailsTregtari tregon të vërtetën e hidhur, shqiptarët hanë më shumë hormone se ushqim (VIDEO)
Klodian Allka është një prej tregtarëve të licencuar në Durrës, i cili përpiqet që të sigurojë prodhime organike, ose me...
Lexo më shumëDetailsAlarm për pilulat e dobësimit, janë vdekjeprurëse
Të ndihemi mirë tek shihemi në pasqyrë është një ndjenjë e përbashkët për të gjithë njerëzit. Por, për ta arritur...
Lexo më shumëDetailsUji në shishe plastike, sa kohë duhet ta pini pas hapjes
Uji në shishe plastike është një nga alternativat e pakta të ujit të pijshëm që konsumatori mund të shfrytëzojë jo...
Lexo më shumëDetails“Mos jepni ilaçe të shtrenjta”, si po i vret shteti shqiptarët që vuajnë nga sëmundjet e zemrës
Nëse pacientët sorollaten për të përfituar me rimbursim “xarelton”, e nga ana tjetër mjekët kërcënohen me vendin e punës apo...
Lexo më shumëDetails